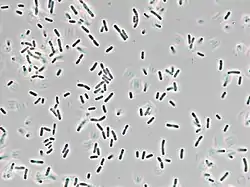

| Delftia tsuruhatensis | ||
|---|---|---|
![]() Delftia tsuruhatensis | ||
| Taxonomía | ||
| Dominio: | Bacteria | |
| Filo: | Pseudomonadota | |
| Clase: | Betaproteobacteria | |
| Orden: | Burkholderiales | |
| Familia: | Comamonadaceae | |
| Género: | Delftia | |
| Especie: | Delftia tsuruhatensis | |
Delftia tsuruhatensis es una bacteria gramnegativa del género Delftia. Fue descrita en el año 2003. Su etimología hace referencia a la región de Tsuruhata, Japón.[1] Es aerobia y móvil. Tiene un tamaño de 0,7-1,2 μm de ancho por 2,4-4,0 μm de largo. Crece de forma individual o en parejas. Temperatura de crecimiento entre 10-40 °C, óptima de 35 °C. Catalasa y oxidasa positivas. Se ha aislado de lodos activados.
Algunos estudios han observado que tiene capacidad para promover el crecimiento de plantas, inhibiendo patógenos y fijando el nitrógeno.[2] Además, también tiene capacidad para degradar varios compuestos contaminantes como fenoles.[3][4][5]
Infecciones en humanos
Puede causar infecciones humanas. Se han descrito casos de bacteriemia y de infección respiratoria.[6][7] Parece que los casos se relacionan con infecciones derivadas de los cuidados sanitarios.[8] Por lo general, puede ser resistente a aminoglucósidos y β-lactámicos. Sensible a ceftriaxona, ertapenem, imipenem, quinolonas y macrólidos.[9] Se ha aislado un bacteriófago lítico de esta especie, el RG-2014.[10]
Referencias
- ↑ Shigematsu, Toru; Yumihara, Kazuyo; Ueda, Yutaka; Numaguchi, Masaki; Morimura, Shigeru; Kida, Kenji (2003-09). «Delftia tsuruhatensis sp. nov., a terephthalate-assimilating bacterium isolated from activated sludge». International Journal of Systematic and Evolutionary Microbiology 53 (Pt 5): 1479-1483. ISSN 1466-5026. PMID 13130036. doi:10.1099/ijs.0.02285-0. Consultado el 27 de septiembre de 2022.
- ↑ Han, Jigang; Sun, Lei; Dong, Xiuzhu; Cai, Zhengqiu; Sun, Xiaolu; Yang, Hailian; Wang, Yunshan; Song, Wei (2005-01). «Characterization of a novel plant growth-promoting bacteria strain Delftia tsuruhatensis HR4 both as a diazotroph and a potential biocontrol agent against various plant pathogens». Systematic and Applied Microbiology 28 (1): 66-76. ISSN 0723-2020. PMID 15709367. doi:10.1016/j.syapm.2004.09.003. Consultado el 27 de septiembre de 2022.
- ↑ Juárez-Jiménez, Belén; Manzanera, Maximino; Rodelas, Belén; Martínez-Toledo, Maria Victoria; Gonzalez-López, Jesus; Crognale, Silvia; Pesciaroli, Chiara; Fenice, Massimiliano (2010-06). «Metabolic characterization of a strain (BM90) of Delftia tsuruhatensis showing highly diversified capacity to degrade low molecular weight phenols». Biodegradation 21 (3): 475-489. ISSN 1572-9729. PMID 19946734. doi:10.1007/s10532-009-9317-4. Consultado el 27 de septiembre de 2022.
- ↑ Zhang, Li-li; He, Dan; Chen, Jian-meng; Liu, Yu (15 de julio de 2010). «Biodegradation of 2-chloroaniline, 3-chloroaniline, and 4-chloroaniline by a novel strain Delftia tsuruhatensis H1». Journal of Hazardous Materials 179 (1-3): 875-882. ISSN 1873-3336. PMID 20417029. doi:10.1016/j.jhazmat.2010.03.086. Consultado el 27 de septiembre de 2022.
- ↑ Juarez Jimenez, B.; Reboleiro Rivas, P.; Gonzalez Lopez, J.; Pesciaroli, C.; Barghini, P.; Fenice, M. (2012-01). «Immobilization of Delftia tsuruhatensis in macro-porous cellulose and biodegradation of phenolic compounds in repeated batch process». Journal of Biotechnology 157 (1): 148-153. ISSN 1873-4863. PMID 21983235. doi:10.1016/j.jbiotec.2011.09.026. Consultado el 27 de septiembre de 2022.
- ↑ Preiswerk, Benjamin; Ullrich, Silvia; Speich, Rudolf; Bloemberg, Guido V.; Hombach, Michael (2011-02). «Human infection with Delftia tsuruhatensis isolated from a central venous catheter». Journal of Medical Microbiology 60 (Pt 2): 246-248. ISSN 1473-5644. PMID 20965913. doi:10.1099/jmm.0.021238-0. Consultado el 27 de septiembre de 2022.
- ↑ Tabak, Omur; Mete, Bilgul; Aydin, Selda; Mandel, Nil Molinas; Otlu, Baris; Ozaras, Resat; Tabak, Fehmi (2013-04). «Port-related Delftia tsuruhatensis bacteremia in a patient with breast cancer». The New Microbiologica 36 (2): 199-201. ISSN 1121-7138. PMID 23686127. Consultado el 27 de septiembre de 2022.
- ↑ Ranc, Alexandre; Dubourg, Grégory; Fournier, Pierre Edouard; Raoult, Didier; Fenollar, Florence (2018-03). «Delftia tsuruhatensis, an Emergent Opportunistic Healthcare-Associated Pathogen». Emerging Infectious Diseases 24 (3): 594-596. ISSN 1080-6059. PMC 5823324. PMID 29460754. doi:10.3201/eid2403.160939. Consultado el 27 de septiembre de 2022.
- ↑ Cheng, Cong; Zhou, Wangxiao; Dong, Xu; Zhang, Peiyao; Zhou, Kexin; Zhou, Danying; Qian, Changrui; Lin, Xi et al. (2021). «Genomic Analysis of Delftia tsuruhatensis Strain TR1180 Isolated From A Patient From China With In4-Like Integron-Associated Antimicrobial Resistance». Frontiers in Cellular and Infection Microbiology 11: 663933. ISSN 2235-2988. PMC 8248536. PMID 34222039. doi:10.3389/fcimb.2021.663933. Consultado el 27 de septiembre de 2022.
- ↑ Bhattacharjee, Ananda Shankar; Motlagh, Amir Mohaghegh; Gilcrease, Eddie B.; Islam, Md Imdadul; Casjens, Sherwood R.; Goel, Ramesh (2017). «Complete genome sequence of lytic bacteriophage RG-2014 that infects the multidrug resistant bacterium Delftia tsuruhatensis ARB-1». Standards in Genomic Sciences 12: 82. ISSN 1944-3277. PMC 5735904. PMID 29270250. doi:10.1186/s40793-017-0290-y. Consultado el 27 de septiembre de 2022.